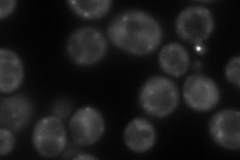
YDL058W
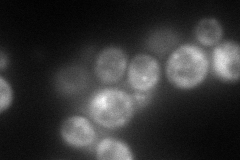
YDL058W
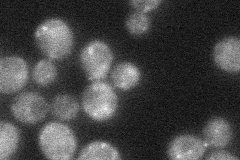
YDL058W
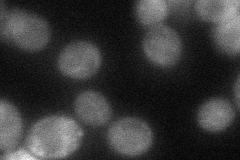
YDL058W

View description
Essential protein involved in intracellular protein transport, coiled-coil protein necessary for transport from ER to Golgi; required for assembly of the ER-to-Golgi SNARE complex
Localization:
Intensity:
Fold change:
Significance:
-
C’ GFP library in SD

punctate33.71 -
N' NOP1pr-GFP in SD
punctate133.018 -
N' TEF2pr-mCherry in SD
cytosol,punctate97.2444 -
N' NATIVEpr-GFP in SD
punctate30.6336 -
N' TEF2pr-VC and Cyto-VN in SD
ambiguous,cytosol54.7756 -
C’ GFP library in SD+DTT

punctate31.510.93No -
C’ GFP library in SD+H2O2

punctate36.131.07No -
C’ GFP library in Starvation Media

punctate34.131.01No -
C’ GFP library on the background of Pup2-DaMP

punctate -
C’ GFP library on the background of CCT mutant

punctate30.66750.909479No
